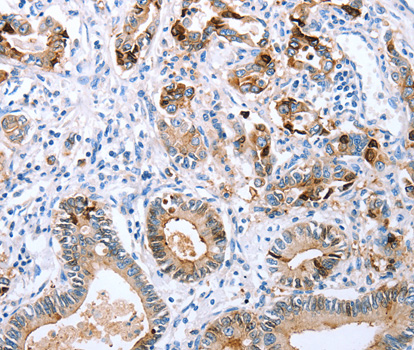
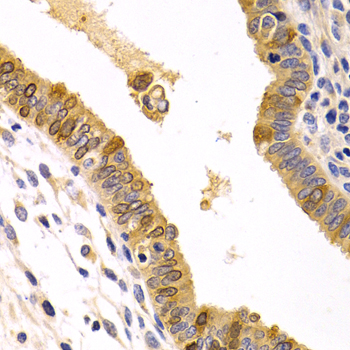
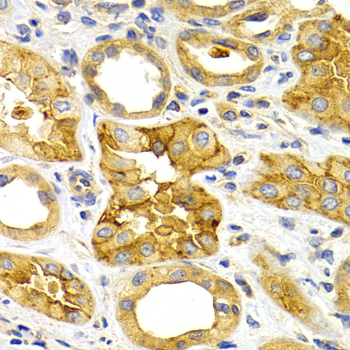

For quotations, please use our online quotation form, and you may also contact us by
service@kendallscientific.com
+1-888.733.6849 (Toll-free)
+1-617.299.7367 (Int’l))
+1-888.733.6849
Our customer service representatives are available 24 hours, Monday through Friday to assist you.| Reactivity | Human Mouse Rat |
| Tested applications | WB IHC |
| Recommended Dilution | WB 1:500 - 1:2000 IHC 1:50 - 1:100 |
| Calculated MW | 46kDa |
| Observed MW | Refer to Figures |
| Immunogen | A synthetic peptide of human CXCR3 |
| Storage Buffer | Store at -20℃. Avoid freeze / thaw cycles. Buffer: PBS with 0.02% sodium azide, 50% glycerol, pH7.3. |
| Synonym | GPR9;MigR;CD182;CD183;Mig-R;CKR-L2;CMKAR3;IP10-R; |

Western blot analysis of extracts of various cell lines, using CXCR3 antibody.
Immunohistochemistry of paraffin-embedded human stomach cancer tissue using CXCR3 antibody.
Immunohistochemistry of paraffin-embedded human metrocarcinoma using CXCR3 antibody at dilution of 1:200 (400x lens).
Immunohistochemistry of paraffin-embedded human kidney cancer using CXCR3 antibody at dilution of 1:200 (400x lens).
The neuronal growth-associated protein GAP43 is also known as neuromodulin, B-50, P-57, F1 and pp46. Deficiency of GAP43 in mice results in death early in the postnatal period. GAP43 is one of the main substrates for protein kinase C in the brain. GAP43 is an intracellular growth-associated protein that appears to assist neuronal pathfinding and branching during development and regeneration, and may contribute to presynaptic membrane changes in the adult, leading to the neurotransmitter release, endocytosis and synaptic vesicle recycling, long-term potentiation, spatial memory formation, and learning. The predicated molecular weight of about 25 kDa is much lower than the apparent observed molecular weight of 43 kDa on SDS-PAGE gels, and this occurs because the highly charged nature of GAP43 causes it to bind less than the average amount of SDS per amino acid, and because the protein has an elongated structure.
N/A